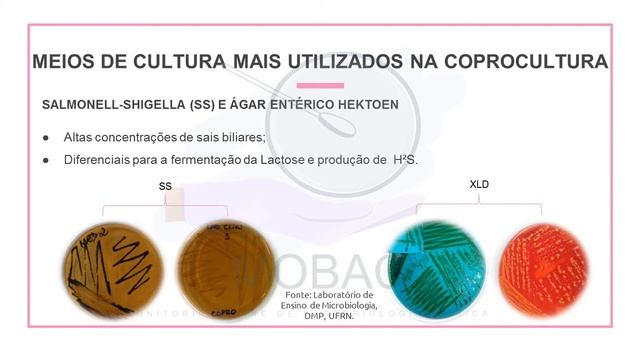
Diagnóstico Laboratorial das Gastroenterites causadas por Enterobactérias смотреть онлайн

Автор / Канал: Забавные эксперименты с псикологическим тестированием Страница 14

ROAD TRIP JOGJA - SITUBONDO PP 1000 KM FULL TOL | MELIHAT UJUNG TIMUR TOL TRANS JAWA | INNOVA DIESE

Alkoller ve Eterler 2 - AYT - 12. SINIF

Калининград — город накрыли сильнейшие проливные дожди, ливнёвки не справляются

да петляй ты к своим мажорам.

BIKIN NAGIH!!! MAKAN DI DAPOER TEMPO DOELOE TEGAL

BIOTIN + COLLAGEN MASKStrengthening Hair TreatmentWeight: 192 mlImported From Dubai

Clinical Governance and Leadership
![Indigo Park Mobile - Escape Room Monster Challenge [ chapter 1] Full Gameplay смотреть онлайн Indigo Park Mobile - Escape Room Monster Challenge [ chapter 1] Full Gameplay смотреть онлайн](https://pic.rtbcdn.ru/video/2024-12-14/66/e5/66e597d4d0d0b1ff85f44a6f053e8e70.jpg)
Indigo Park Mobile - Escape Room Monster Challenge [ chapter 1] Full Gameplay

Избери the Green side of cola!

Software Testing Life Cycle - STLC and STLC Phases | ArtOfTesting

Едем в Ставрополь

Unboxing & Review (Lagi) Melamin Golden Dragon

Carmina Burana 2.

MCQ for Biochemistry (part 1) by Avrendra Singh (Ans. of Q11- D)

Miss Ann's Tempo

Простой рецепт! Минимум ингредиентов! Говядина с луком! Тушеная по-еврейски.#говядинаслуком

Divine Bounty Super B Complex Vitamins All B Vitamins Including B12, B1, B2, B3, B5, B6, B7, B9
Diagnóstico Laboratorial das Gastroenterites causadas por Enterobactérias
![Comparing QL-7, QL-5, & QL-2... Where to farm if you suck at dodging??? [Punishing Gray Raven] смотреть онлайн Comparing QL-7, QL-5, & QL-2... Where to farm if you suck at dodging??? [Punishing Gray Raven] смотреть онлайн](https://pic.rtbcdn.ru/video/2025-02-18/89/eb/89eb8c09ad0dd1e5d5d77808a1602fba.jpg)
Comparing QL-7, QL-5, & QL-2... Where to farm if you suck at dodging??? [Punishing Gray Raven]

373 - Generating More Sales With Linkedin Outreach With Stefan Smulders

RACE 3 Actor Bobby Deol Spotted With Friends At Indigo Juhu

ORGANIC CHEMISTRY NTA ABHYAS-2

Dr. Zakir Naik - Women's Rights In Islam - CD4-03.mp4

Manitowoc Full Size Cube Ice Machine - Indigo Series w/ Hotel Dispenser Video (ID-0322A_SFA-191)
За каждым успешным каналом стоит личность, идея и сотни часов кропотливого труда. Если вы здесь, значит, автор «Забавные эксперименты с псикологическим тестированием» уже сумел зацепить ваше внимание своим уникальным стилем или подачей. А мы на RUVIDEO позаботились о том, чтобы вы могли изучить весь архив его работ в максимально комфортных условиях — без лишней суеты и преград.
Почему за работами канала «Забавные эксперименты с псикологическим тестированием» так интересно наблюдать? Всё просто: это честный контент, который находит отклик в сердцах зрителей. На нашем ресурсе вы можете смотреть онлайн все видео любимого автора бесплатно и в хорошем качестве. Нам важно, чтобы вы видели каждую деталь и слышали каждый нюанс, поэтому мы используем только стабильные плееры из открытых источников Rutube.
Следите за новинками канала, пересматривайте старые шедевры и открывайте для себя новые грани творчества «Забавные эксперименты с псикологическим тестированием». Мы постоянно обновляем ленту, чтобы у вас под рукой всегда были самые свежие выпуски. Никаких сложных регистраций — только вы и творчество, которое вдохновляет. Приятного вам путешествия по миру авторского контента на RUVIDEO!
Видео взято из открытых источников Rutube. Если вы правообладатель, обратитесь к первоисточнику.